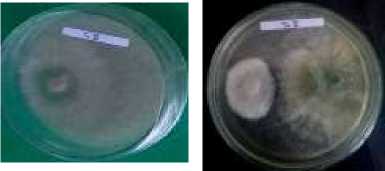
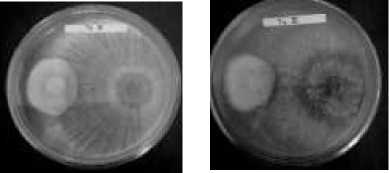

PATHOGENITY TESTING OF THE MUSHROOMS Trichoderma spp. SOME PLANTATION LAND IN CONTROLLING Fusicoccum sp DISEASE OF TOBACCO PLANT
on
Pathogenicity Testing of Trichoderma spp. From Different Plantations To Control Tobacco Plant Diseases Caused By Fusicoccum sp.
Lubis, E, Novita, A. & Phuoc, L.H.
PATHOGENICITY TESTING OF Trichoderma spp. FROM DIFFERENT PLANTATIONS TO CONTROL TOBACCO PLANT DISEASES CAUSED BY Fusicoccum sp.
Efrida Lubis1*, Aisar Novita1, Le Huu Phuoc2
1Department of Agrotechnology, Faculty of Agriculture, Universitas
Muhammadiyah Sumatera Utara, Jl. Muhtar Basri No.3, Kecamatan Medan Timur, Kota Medan, Sumatera Utara, 20238, Indonesia 2Department of Crop Science, Faculty of Agriculture and Natural Resources, An Giang University, No 18, Ung Van Khiem street, Dong Xuyen ward, Long Xuyen City, An Giang Province, Vietnam *Corresponding Author Email: efridalubis@umsu.ac.id
ABSTRAK
Received:
15 March 2023
Accepted:
19 July 2022
Published:
1 August 2023
Trichoderma spp. are saprophytic fungi in soils that are naturally parasitic to and attack numerous plant diseasecausing fungi or have a broad spectrum of control. This study aimed to obtain superior isolates of Trichoderma spp. as fungal antagonists from several plantation areas in North Sumatra, Indonesia. A non-factorial, completely randomized design comprising seven treatments made in triplicate was employed, including no treatment or control (T0) and isolates of Trichoderma spp. from several plantations: rubber (T1), oil palm (T2) and cocoa in Langkat Regency (T3), oil palm in Percut Sei Tuan, Deli Serdang Regency (T4), and coffee (T5) and cocoa in Karo Regency (T6). After macroscopic and microscopic identification, the percentage of inhibition against Fusicoccum sp. was determined, and the pathogenicity of these isolates was tested on tobacco plants. Results indicate that isolates from the rubber plantation in Langkat (T1) produced the highest percentage of inhibition against Fusicoccum sp. and showed a negative reaction in the pathogenicity test as no necrotic spots were formed on tobacco leaves after injection.
Keywords: Trichoderma spp., Fusicoccum sp, percentage of inhibition.
INTRODUCTION
Soil-borne pathogens cannot be effectively and efficiently curbed by solely relying on synthetic pesticides that target parts of plants because they live in the soil and attack when their environment is in favorable conditions. Besides, these pesticides can lead to
environmental pollution, ecological disturbances or imbalance, and even various health problems when used excessively. For these reasons, more target-specific and environmentally friendly methods are needed to control the pathogens to protect plants longterm, including reducing chemical
pesticides and replacing them with natural antagonist agents as biological control. Biological control is introduced as an alternative means of suppressing the growth of pathogens with little to no negative influence on the environment using biological agents, such as viruses, fungi, and bacteria. Trichoderma is one of the soil fungi with a scientifically proven ability to control plant diseases.
Trichoderma spp. are an antagonist agent that can substantially inhibit the growth and spread of pathogenic fungi (Mariana and Budi, 2013) through mycoparasitism, antibiosis, or competition (Fitriani, et. al., 2017). They grow rapidly and can be hyperparasites to many species of fungi that cause plant diseases. During unfavorable conditions such as drought or lack of nutrients, Trichoderma produces propagules called chlamydospores that will be dormant and only forms new individual organisms once exposed to a suitable environment. Therefore, they will remain in the soil even with a single application. This is one of the advantages of using Trichoderma as a biological control agent, especially for soil-borne pathogens (Berlian, et.al. 2013).
This research investigated the potential use and benefit of Trichoderma spp. as soil organisms that can reduce or mitigate diseases in tobacco plants. Exploring the natural enemies of pathogenic fungi is the first step to implementing biological control, as this allows development, reproduction, and conservation. Exploration activities can include looking for specimens in the field, e.g., insects that are healthy or suspected of being infected by entomopathogenic fungi, plant parts (leaves, roots, stems),
and the soil around the plant (Darmawan, 2016).
For the above purpose, isolates of Trichoderma spp. were collected from several plantation areas, including rubber plantations with the most cases of leaf blights. Corynespora, Oidium, and
Colletotrichum are responsible for blights in rubber plantations in Indonesia. However, global climate change has turned what was previously not very severe into an endemic, namely the outbreak of leaf blights caused by Fusicoccum sp. This incident first occurred in April 2017 in North Sumatra because, compared to other parts of Indonesia, it is relatively close to Malaysia. Fusicoccum sp. has been attacking nearly all rubber plantations in the area ever since. This pathogen causes leaf browning and then the death of plant tissues, resulting in little to no canopy area throughout the year (Fairuzah, 2015).
METHODOLOGY
The research materials were isolates of Trichoderma spp. from various plantation areas, potato dextrose agar (PDA) for the growth medium, 96% alcohol, isolates of other pathogens, denatured alcohol, distilled water (Aqua Dest), and
chloramphenicol. The equipment included Petri dishes, Erlenmeyer flasks, test tubes, a vortex mixer, object glasses, Bunsen lamps, an autoclave, analytical balance, a laminar flow cabinet, a microscope, and inoculation needles. The tools used during sampling in the field were cork drills, hoes, stationery, and cameras.
This research employed a nonfactorial, completely randomized design (CRD) with seven treatments: T0 = control
T1 = Isolate of Trichoderma spp. from a rubber plantation in Langkat Regency
T2 = Isolate of Trichoderma spp. from oil palm plantation in Langkat Regency
T3 = Isolate of Trichoderma spp. from a cocoa plantation in Langkat Regency T4 = Isolate of Trichoderma spp. from oil palm plantation in Percut Sei Tuan, Deli Serdang Regency
T5 = Isolate of Trichoderma spp. from a coffee plantation in Karo Regency T6 = Isolate of Trichoderma spp. from cocoa plantation Karo Regency
RESULTS AND DISCUSSION
Identification of Trichoderma spp.
The fungal antagonist
exploration yielded six isolates of Trichoderma spp. from rubber, oil palm, cocoa, and coffee plantations in three locations in North Sumatra. The description of these isolates, as well as their origin, host, and source plant, is summarized in Table 1. The identification process revealed different macroscopic and microscopic characteristics.
Macroscopic observations on the isolates cultured in the growing media (PDA) found green, dark green, and yellowish-green colonies,
indicating that the collected isolates were indeed those of Trichoderma spp. [6]. During their growth, these colonies changed color from transparent white to slightly greenish-white, light green, green, then dark green after seven days. It only took about one week to fill the entire Petri dish and transform the colony’s color into green or yellow, suggesting rapid growth. In addition to color, the colonies also developed into circular patterns that are visible in light. This corresponds to most members of the genus Trichoderma (Gusnawaty, et.al. 2014).
Table 1. Exploration results of isolates from different plantation crops and locations.
|
Isolate Name |
Origin |
Host |
Source Plant |
|
TR.RU. |
Langkat |
Dilution |
Rubber |
|
L.1 |
Regency |
from soil | |
|
TR.PO. |
Langkat |
Dilution |
Palm oil |
|
L.1 |
Regency |
from soil | |
|
TR.CO. |
Langkat |
Dilution |
Cocoa |
|
L.1 |
Regency |
from soil | |
|
TR.PO. |
Percut Sei |
Dilution |
Palm oil |
|
P.1 |
Tuan, Deli Serdang Regency |
from soil | |
|
TR.CF. |
Karo |
Dilution |
Coffee |
|
K.1 |
Regency |
from soil | |
|
TR.CO. |
Karo |
Dilution |
Cocoa |
|
K.1 |
Regency |
from soil |
As explained by (Purwantisari and Hastuti, 2009), Trichoderma spp. cultures generally grow and produce conidia within a week. Microscopic observations identified conidia in round or circular clusters with erect and branched conidiophores. (Suharjo, et.al. 2015) added that the genus Trichoderma morphologically consists of green to dark green colonies with slightly round to round conidiophores and pumpkin-shaped phialides with branching conidiophores. According to (Gusnawaty, et.al. 2014) these branches are pyramid-shaped, longer at the bottom of lateral branches and shorter approaching the top.
Other reported morphological features include slender and elongated phialides and semi-spherical to oval, smooth-walled conidia. The colonies are white at the first stage of their growth, then turn greenish. After maturity, the mycelium appears yellowish-green or dark green, especially on the part with a lot of conidia.

SS
Pi

TR.CO.K.1 TR.CF.K.1 TR.PO.P.1 TR.CO.L.1 TR.PO.L.1 TR.RU.L.1


Figure 1. Macroscopic appearances of six isolates of Trichoderma spp. obtained during the exploration: front/left sections (left) and rear/right sections (right).
Source: Research Documentation (Live Photo)

Figure 2. Microscopic appearances of six isolates of Trichoderma spp. at 10x (left) and 100x magnification (right).
Source: Research Documentation (Live Photo)
Percentage of Inhibition for Fusicoccum sp.
Leaf blight treatments with Trichoderma spp. started to show significant effects three days after inoculation, with increasing %inhibition toward the end of the
observation (Day 9). Table 2 and Figure 3 show the observation results from one to nine days after inoculation for the control and six treatments. These data were used to determine which treatment(s) hampered the mycelial growth of Fusicoccum sp. most effectively.
Table 2. Inhibitory activities of isolates of Trichoderma spp.
against Fusicoccum sp.
|
Treatment 1 |
% Inhibition on the i-th day after inoculation | ||||||||
|
2 |
3 |
4 |
5 |
6 |
7 |
8 |
9 | ||
|
0.30 |
0.60 |
1.53 |
2.17 |
2.63 |
3.30 |
4.40 |
5.33 |
6.00 | |
|
T0 |
0.89 |
(1.05a) |
(1.43a) |
(1.63a) |
(1.63a) |
(1.94a) |
(2.21a) |
(2.41a) |
(2.55a) |
|
T1 |
0.11 |
0.16 |
0.52 |
0.65 |
0.71 |
0.76 |
0.83 |
0.86 |
0.87 |
|
0.78 |
(0.81b) |
(1.01b) |
(1.07b) |
(1.07b) |
(1.12b) |
(1.15b) |
(1.17b) |
(1.17b) | |
|
0.08 |
0.12 |
0.35 |
0.51 |
0.58 |
0.66 |
0.75 |
0.79 |
0.82 | |
|
T2 |
0.76 |
(0.79b) |
(0.92b) |
(1.01b) |
(1.01b) |
(1.04b) |
(1.12b) |
(1.14b) |
(1.15b) |
|
0.08 |
0.12 |
0.30 |
0.49 |
0.57 |
0.65 |
0.74 |
0.79 |
0.82 | |
|
T3 |
0.76 |
(0.79b) |
(0.89b) |
(0.99b) |
(0.99b) |
(1.03b) |
(1.11b) |
(1.14b) |
(1.15b) |
|
0.06 |
0.10 |
0.37 |
0.55 |
0.62 |
0.69 |
0.77 |
0.82 |
0.84 | |
|
T4 |
0.71 |
(0.78b) |
(0.93b) |
(1.02b) |
(1.03b) |
(1.06b) |
(1.13b) |
(1.15b) |
(1.16b) |
|
T |
0.08 |
0.10 |
0.35 |
0.53 |
0.61 |
0.68 |
0.76 |
0.81 |
0.83 |
|
T5 |
0.76 |
(0.77b) |
(0.92b) |
(1.02b) |
(1.01b) |
(1.05b) |
(1.12b) |
(1.14b) |
(1.15b) |
|
T6 |
0.06 |
0.10 |
0.35 |
0.51 |
0.60 |
0.67 |
0.76 |
0.80 |
0.83 |
|
0.71 |
(0.77b) |
(0.92b) |
(1.01b) |
(1.0b) |
(1.05b) |
(1.12b) |
(1.14b) |
(1.15b) | |
Notes: Numbers followed by different letters in the same column differ significantly from one another at a 1% significance level according to Duncan's multiple range test (DMRT). Numbers in parentheses are the result of the transformation (P+0.5)

Figure 3. Histogram of % inhibition of the mycelial growth of Fusicoccum sp.
The control (T0) showed the best figures that increased from 0.30 on Day 0 to 6.00 on Day 9, significantly different from the six treatments. Isolates from the rubber plantation in
Langkat (T1) constantly produced the highest %inhibition throughout the observation period, from up to 52% (0.52) on Day 3. On the contrary, isolates from the cocoa plantation in
Langkat (T3) exhibited the lowest inhibitory activity against Fusicoccum sp. from 30% (0.30) on Day 3 to 49% (0.49) on Day 4. Then, more than half of the fungi stopped growing on Day 5 (0.57). At the end of the observation, all the treatments successfully impeded 80% of the pathogen’s growth: T1 (0.87), T2 (0.82), T3 (0.82), T4 (0.84), T5 (0.83), and T6 (0.83).
From one to nine days after inoculation, it was found that isolates of Trichoderma sp. from the rubber
T0 (Control) T1

T4
Figure 4. Visual appearances of the inhibited growth of the pathogenic fungus Fusicoccum sp. after treatments with six isolates of Trichoderma spp. Source: Research Documentation (Live Photo)
From the percentage, histogram, and visual appearance of growth inhibition in Table 2, Figure 3, and Figure 4, it can be inferred that Trichoderma spp. have the ability to inhibit and suppress the growth of the pathogenic fungus Fusicoccum sp. The dual culture method in this research allows Trichoderma spp. to interact with Fusicoccum sp. directly and stop its mycelial growth three days after inoculation. This antagonistic activity stems from the parasitic nature of Trichoderma spp. Further, (Khairul, et.al., 2017) stated that this genus of fungi could secrete antibiotic compounds to act as antifungals that inhibit growth and even turn into
plantation in Langkat (TR.RU.L.1) produced the best inhibition of Fusicoccum sp. infestations (T1). Therefore, the treatments using isolates of Trichoderma sp. from different plantation areas in the order of the most to the least effective are as follows: T1 (rubber, Langkat), T4 (oil palm, Percut Sei Tuan), T5 (coffee, Karo), T6 (coffee, Karo), T2 (oil palm, Langkat), and T3 (cocoa, Langkat).
T2 T3

T5 T6
mycoparasites upon reacting with the pathogenic fungus Colletotrichum capsica that covered the entire surface of the growing medium only six days after inoculation. According to (Berlian, et. al., 2013), this antagonistic activity occurs through mycoparasitism and aggressive competition. Both the parasitic nature and antibiotic compounds make Trichoderma spp. capable of parasitizing (i.e., attacking and taking nutrients from) plant pathogenic fungi (Purwantisari, 2009).
Trichoderma spp. give more advantages as biological agents than other fungi because they grow and
propagate rapidly. Moreover, several types of Trichoderma spp. can survive unfavorable conditions and are resistant to fungicides and herbicides.
Pathogenicity Test against Tobacco Plants
Figure 5 and Table 3 show the pathogenicity test results of Trichoderma spp. on tobacco plants. Isolates of Fusarium sp. (positive control) produced necrotic spots on the leaves (positive reaction). According to (Kurniawati, et. al., 2015), an isolate infiltrating tobacco leaves starts showing symptoms of necrosis within 24 hours and can cause diseases afterward. In general, the results show a negative reaction, meaning that Trichoderma spp. do not cause or contribute to the development of necrotic spots on tobacco leaves.

Figure 5. Pathogenicity test on tobacco leaves injected with Trichoderma spp.
(left), infected by Fusarium sp. as positive control (middle), and injected with distilled water as negative control (right).
Source: Research Documentation
Table 3. Pathogenicity test results of Trichoderma spp. on tobacco leaves Reaction
|
Treatment |
Necrotic spots (+) |
No necrotic spots (-) |
|
Positive control |
√ |
x |
|
(Fusarium sp.) | ||
|
Negative control |
x |
∕ |
|
(Aqua Dest) | ||
|
T1 (TR.KR.L.1) |
x |
√ |
|
T2(TR.KS.L.1) |
x |
√ |
|
T3(TR.C.L.1) |
x |
√ |
|
T4(TR.KS.P.1) |
x |
√ |
|
T5(TR.K.K.1) |
x |
≠ |
|
T6(TR.C.K.1) |
x |
√ |
CONCLUSION
Trichoderma spp. have been isolated from six different plantation crops and areas. Isolates from the rubber plantation in the Langkat Regency (T1) have the best inhibitory activities against the mycelial growth of Fusicoccum sp.—i.e., the cause of leaf blights. The pathogenicity test revealed that Trichoderma spp. can inhibit blights in tobacco leaves. Isolates from the rubber plantation in Langkat (T1) produced the highest percentage of inhibition against Fusicoccum sp. and showed a negative reaction in the pathogenicity test as no necrotic spots were formed on tobacco leaves after injection
REFERENCES
Berlian, I., Setyawan, B., and Hadi, H. 2013. Mekanisme Antagonisme Trichoderma spp. terhadap Beberapa Patogen Tular Tanah. Warta Perkaretan 2013, 32(2),
74–82.
Darmawan, E. 2016. Eksplorasi Jamur Entomopatogen Beauveria
Bassiana, Metarrzihum Anisopliae dan Jamur Antagonis Trichoderma sp. pada Beberapa Sampel Tanah Pertanaman Tembakau. Digital Repository Universitas Jember.
Fairuzah, Z. 2015. Identifikasi Perbedaan Serangan dan Konidia Penyakit Daun Colletotrichum dan Fusicoccum pada Tanaman Karet. Scientific Note. Balai Penelitian Sungei Putih (Unpublished).
Fitriani, Suryantini, R., and Wulandari, R.S. 2017. Pengendalian Hayati Patogen Busuk Akar
(Ganoderma Sp.) Pada Acacia Mangium dengan Trichoderma spp. Isolat Lokal Secara In Vitro. Jurnal Hutan Lestari Vol. 5 (3): 571–570.
Gusnawaty, H., Taufik, M., Triana, L., and Asniah. 2014. Karakterisasi Morfologis Trichoderma spp. Indigenus Sulawesi Tenggara. Jurnal Agroteknos Juli 2014 Vol. 4 No. 2: 87–93 ISSN: 2087-7706.
Perkebunan Sawit (BPDPKS).
Lampung.
Khairul, I., Montong, V.B., and
Ratulangi, M.M. 2017. Uji
Antagonisme Trichoderma sp. terhadap Colletotrichum capsici Penyebab Penyakit Antraknosa pada Cabai Keriting Secara In Vitro .Jurnal Hama dan Penyakit Fakultas Pertanian, Samratulangi. p. 6–8. 846539.
Kurniawati, S., Kikin, H.M., and Giyanto. 2015. Eksplorasi dan Uji Senyawa Bioaktif Bakteri Agensia Hayati untuk
Mengendalikan Kresek pada Padi. Jurnal HPT Tropika Volume 15 Nomor 2: 170–179. ISSN 1411-7525.
Mariana and Budi, I.S. 2013. Eksplorasi Cendawan Antagonis terhadap Ganoderma sp.
Penyebab Penyakit Busuk
Pangkal Batang Kelapa Sawit. Vol. 20 No. 2.
Purwantisari S. 2009. Isolasi dan Identifikasi Cendawan
Indigenous Rhizosfer Tanaman Kentang dari Lahan Pertanian Kentang Organik di Desa Pakis. Magelang. Jurnal BIOMA. 11
(2): 45.
Purwantisari, S., and Hastuti, R.B. 2009. Uji Antagonisme Jamur Patogen Phythopthora infestans Penyebab Penyakit Busuk Daun dan Umbi Tanaman Kentang dengan Menggunakan
Trichoderma spp. Isolat Lokal. Bioma. Vol. 11, No. 1: 24–32
Suharjo, R., Fitriana Y., Rini, M.V., and Hidayat, K.F. 2015.
Karakterisasi dan Identifikasi Isolat Jamur Trichoderma sp. Terpilih. Badan Pengelola Dana
32
Discussion and feedback